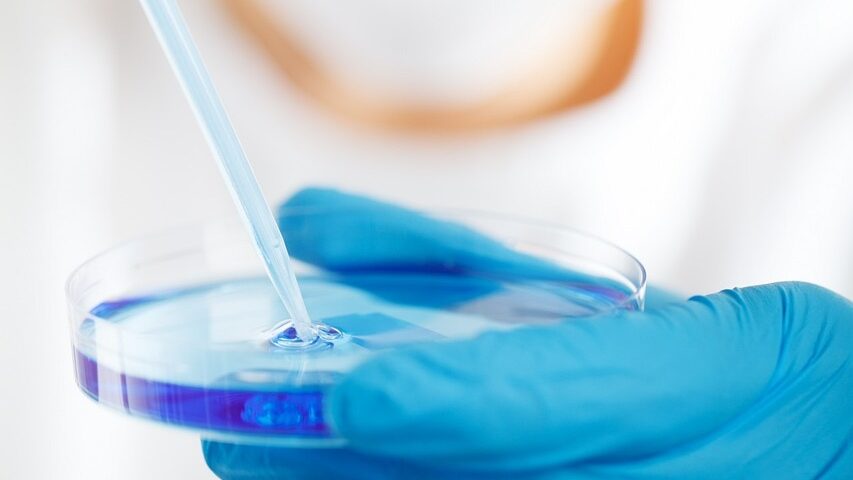

Procesado
La agricultura celular es una tecnología clave para la seguridad alimentaria
08 Marzo, 2023
Análisis hechos por GlobalData destacan la importancia de la agricultura celular en la seguridad alimentaria vinculada a la disponibilidad de proteínas
Se estima que la población mundial aumentará hasta alcanzar los 10 mil millones para 2050. En este contexto, la demanda de un sistema alimentario sostenible para satisfacer las necesidades mundiales de proteínas va en aumento. La "agricultura celular" está emergiendo como una de las tecnologías clave para descarbonizar los sistemas de producción de proteínas. Esta se basa en la producción directa de productos a partir de células, en lugar de criar un animal para sacrificarlo o cultivar, dice GlobalData, una empresa líder en análisis y datos.
Misa Singh, analista de fundamentos comerciales de GlobalData, comenta:
“La agricultura celular es una solución emergente para las proteínas alternativas. Gobiernos y empresas están promoviendo inversiones en el campo. El gobierno holandés ha anunciado una inversión de EUR60 millones en el campo. La FDA de EE. UU. emitió la primera carta de "Sin preguntas" sobre la seguridad del producto de pollo cultivado de UPSIDE Foods".Australian Ethical Investment habla sobre el apoyo al crecimiento de los mercados alternativos de proteínas (carne a base de plantas y agricultura celular) para minimizar la presión sobre la deforestación, las emisiones de carbono y el sufrimiento animal. Un análisis de la base de datos de análisis de archivos de empresas de GlobalData revela que empresas como Agronomics y SEED Innovations están realizando inversiones enfocadas en producir y comercializar productos agrícolas celulares. SEED Innovations invirtió 125 000 EUR en Clean Food Group. Se trata de una empresa de biotecnología centrada en la agricultura celular y la comercialización de la producción de aceite de palma bioequivalente por fermentación. Agronomics invirtió en CellX Ltd, una empresa china que produce carne cultivada Empresas como Agronomics indican que la agricultura animal produce el 18% de las emisiones de gases de efecto invernadero del mundo. Además, el 12% de estas emisiones provienen de la deforestación realizada para cultivar. Esto ha acelerado la necesidad de tecnologías para reducir estas emisiones, y la agricultura celular podría surgir como una solución efectiva. Las empresas también se están asociando para ayudar a acelerar la creación de carne cultivada asequible. Qkine se ha asociado con 3DBT para combinar su tecnología de ingeniería de proteínas con el suplemento de medios libres de animales City-Mix de 3DBT para cultivar células musculares y grasas para la producción en masa de carne cultivada asequible. Singh concluye:
“La demanda de proteínas amenaza con sobrepasar la oferta, y la agricultura celular es una opción sostenible emergente que limita las emisiones de efecto invernadero que afectan el clima. Sin embargo, las empresas y los inversores deben tener en cuenta los procesos biológicos impredecibles que intervienen en el bioprocesamiento del cultivo de células y tejidos junto con los riesgos asociados a los retrasos, los suministros o los servicios necesarios para la investigación y el desarrollo”.Fuente https://www.globaldata.com/marketplace/dataset/globaldata-company-filings/















.gif)



